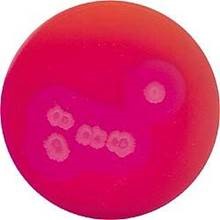
291216.jpg 291216.jpg

З метою гармонізації вітчизняного законодавства у сфері контролю якості продуктів харчування було прийнято наказ №548 «Про затвердження Мікробіологічних критеріїв для встановлення показників безпечності харчових продуктів», який набув чинності у 2015 році. Хоча наказ прийнятий досить давно, далеко не всі виробничі лабораторії визначають зазначені показники згідно вказаних методик.
Розглянемо, що представляє собою мікроорганізм, який потрібно визначати, чим він небезпечний і головне – як його виділяти відповідно до вимог законодавства.
Що визначати, де і як?
Bacillus cereus – грампозитивна велика паличка, факультативний анаероб, що утворює ендоспори.
«Шукати» її потрібно:
- В сухих сумішах для дітей грудного віку
- Сухих дієтичних харчових продуктах для спеціальних медичних потреб, призначених для дітей грудного віку (молодше шести місяців)

Характеристика мікроорганізму
B. cereus широко розповсюджена в навколишньому середовищі, часто висівається з ґрунту та рослин. Здатна утворювати спори за несприятливих умов: вони можуть існувати без поживних речовин та утворювати вегетативні форми при більш високих температурах.
Оптимальні умови навколишнього середовища :
- Оптимальна температура для росту – від 28°C до 35°C
- Мінімум для росту – 4°C, максимум – 48°C
- Ріст можливий за рівня pH від 4,9 до 9,3
- Мікроорганізми толерантні до концентрації солей 7,5%
Біохімічні характеристики:
- Каталаза +, ферментує глюкозу, сахарозу, саліцин і гліцерол
- Не ферментує маннітол та арабінозу
- Утилізує нітрати до нітритів, продукує лецитіназу
Які інфекції викликає Bacillus cereus?
Бактерія може викликати два типи токсикоінфекцій:
- Діарейний: виникає при вживанні контамінованої їжі, коли бактерія виділяє токсини в тонкому кишківнику. Ця форма може проявлятися діареєю, кольками й іноді нудотою, але зазвичай без блювоти.
- Блювотний: виникає якщо B. cereus виділяє різні типи токсинів в контамінованій їжі. Нудота та блювання виникають через декілька годин після отруєння.
Обидва типи хвороби, як правило, проходять самостійно, проте можуть виникати серйозні ускладнення (хоча й рідко), навіть у здорових людей. Як і у випадку з будь-якими іншими інфекціями, люди зі слабкою імунною системою (які мають хронічні захворювання чи приймають ліки, що послаблюють імунну систему) набагато частіше страждають від серйозних наслідків даної токсикоінфекції.
Чим небезпечна B. cereus для новонароджених
Аліментарний шлях зараження «виливається» гострим гастроентеритом. При зараженні контактим шляхом може розвинутися менінгіт, бронхопневмонія, остеомієліт, абсцес мозку, панофтальміт, ендокардит, сепсис, бактеріємія.
Де може «ховатися» B. cereus?
Різні види харчових продуктів, включаючи м'ясо, молочні продукти, овочі та рибу, можуть викликати харчове отруєння за наявності B. cereus. Напад блювоти зазвичай пов'язують з уживанням зараженого рису та інших крохмаловмісних продуктів, таких, як картопля та ін. Суміші продуктів – соуси, пудинги, супи, запіканки, випічка та салати – часто пов'язують із харчовими отруєннями, асоційованими з B. сereus. У немовлят отруєння можливі через вживання контамінованих сумішей та контактом із зараженим медичним приладдям (катетери, зонди тощо).
Як можна попередити передачу інфекції аліментарним шляхом
- Охолоджувати теплу нез’їдену їжу так швидко, як це можливо, але не довше 2-х годин після приготування, до +4ºC. Якщо охолодження не можливе, страви мають знаходитись при +65ºC до використання.
- Зберігати та обробляти сировину, напівготові та готові продукти при температурі нижче 7ºC.
- Зниження рН і активності води приготовленої їжі обмежує зростання бактерій (бактерії не будуть рости за низького рН або при активності води нижче 0,93).
- Для зниження ризику контамінації життєво важливо підтримувати чистоту в місцях приготування їжі.
- Слід уникати зберігання сировини та приготованої їжі занадто довго.
Як ідентифікувати B. Cereus: алгоритм
Для виявлення, обліку та підтвердження B. cereus в продуктах харчування існує ряд методів. Метод, що застосовується для виявлення Bacillus cereus згідно наказу №548, прописаний в ISO 7932:2004 "Мікробіологія продуктів харчування та кормів для тварин". Горизонтальний метод підрахунку Bacillus cereus на чашках при 30 °С.
Розглянемо черговість дій при визначенні B. Сereus згідно даного методу.
- Кількісний облік та селективна ізоляція B. Cereus на селективному агарі (основа) ( MYP)
- Сіємо 0,1 мл первинного та наступних розведень на чашку Петрі з основою Bacillus Cereus селективного агару, доповненого емульсією яєчного жовтка та поліміксином.
- Інкубуємо протягом 18-24 та 48 год при 30 ºC.
- Підраховуємо імовірні колоній B. cereus на кожній чашці. Імовірні колонії – великі, рожеві (вказують на відсутність ферментації манніту) та зазвичай оточені зоною преципітації (вказують на продукцію лецитінази) .
- Підтвердження на основі кров’яного агару Nº2
- Вибираємо 3 ізольовані колонії та вносимо на чашки з кров'яним агаром №2, приготованим з 5-7% стерильної дефібринованої крові.
- Інкубуємо протягом 24±2 год при 30ºC.
- Зона гемолізу навколо колоній вказує на B.cereus, бо ці бактерії синтезують гемолізин, який утворює зону лізису навколо колоній.
- Інтерпретація результатів
Кількість бактерій в г чи мл продукту обчислюється за формулою:N= M x 1/D,
де:
N – кількість мікроорганізмів/г чи в мл зразка;
D – фактор розведення на обраній чашці;
M – кількість мікроорганізмів на чашці. - Позначення відсутності росту
- Не виявлено в рідкому продукті – позначається < 1 КУО/мл.
- Не виявлено в твердому продукті – позначається < 10 КУО/мл.
| Деякі штами B. Cereus продукують замало лецитінази. Колонії цих штамів не оточені зоною преципітату. Такі колонії також мають бути враховані в підтверджуючих тестах. |
Сподіваємось, що допомогли у висвітленні незрозумілих питань виділення та культивування B. сereus. Для впровадження даного методу звертайтесь безпосередньо до стандарту.
Анна Журба,
спеціаліст відділу витратних матеріалів
ТОВ «ХІМЛАБОРРЕАКТИВ»